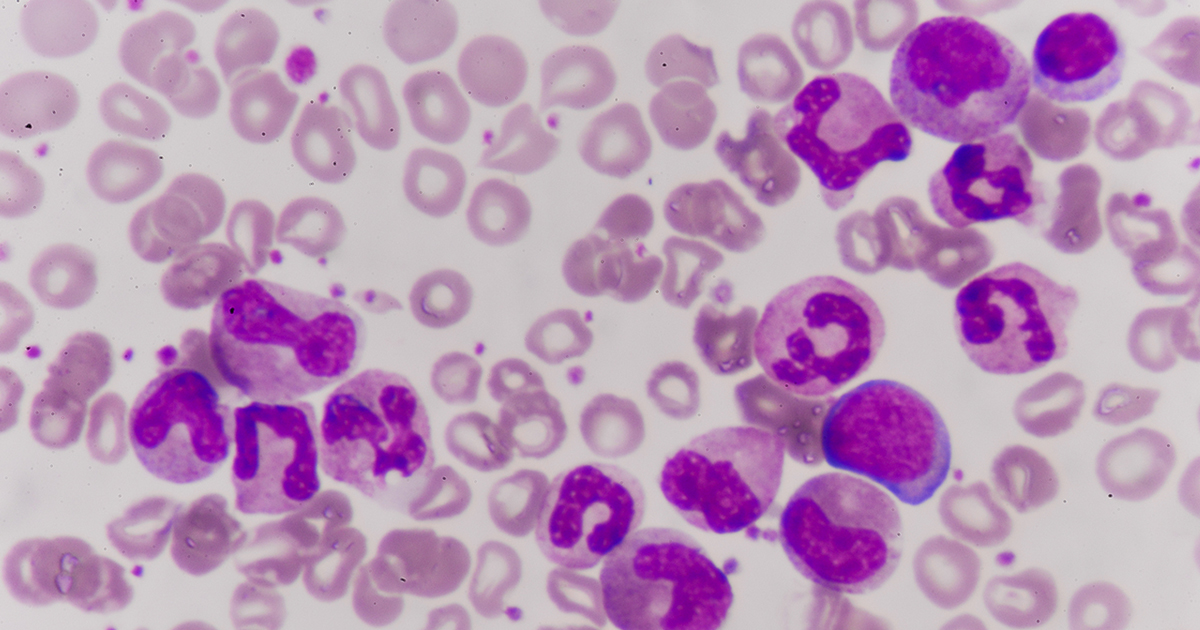

Acute Lymphoblastic Leukemia Overview
White blood cells, also known as lymphocytes, are part of the immune system and are necessary to protect the body from foreign material and harmful microorganisms. White blood cells are made in the bone marrow, the tissues inside the bones, along with all other blood cells. Acute lymphoblastic leukemia (ALL), also sometimes referred to as acute lymphocytic leukemia is the form of cancer that prevents the lymphocyte from doing its job properly.
Start reading now to learn the basics about the condition, along with details on symptoms and everything else patients need to know about ALL.
Condition Basics
At the very beginning of a lymphocyte's life, it is called a lymphoblast. So, technically lymphoblast and lymphocyte are are both referring to a young white blood cell. This is why acute lymphoblastic leukemia is also occasionally called acute lymphocytic leukemia. The term âacuteâ means quick. So, if not treated, this cancer spreads quickly and can be fatal within a few months.
This cancer affects the blood and bone marrow. In fact, the cancerous lymphoblasts are overproduced in the bone marrow, so they use up all the resources and then crowd and kill the normal lymphocytes. ALL spreads from the bone marrow through the blood to other parts of the body, a process called metastasis.
Continue reading to learn about the symptoms of acute lymphoblastic leukemia.
Symptoms

The beginning symptoms of acute lymphoblastic leukemia can, unfortunately, be quite vague, at least in the beginning. These vague symptoms include fever, night sweats, fatigue, and loss of appetite or weight. If the patient has a shortage of red blood cells due to ALL, their symptoms can mimic those of anemia, and include shortness of breath, dizziness, feeling cold, lightheadedness, and weakness. A shortage of white blood cells in this condition causes an increase in the frequency of infections, and often fever as well. Other symptoms of acute lymphoblastic leukemia include trouble breathing, joint or bone pain, blurred vision, headaches, issues with balance, and enlarged lymph nodes (e.g., in the groin, neck, or armpits). These symptoms vary based on where cancer spreads in the patient.
Continue reading to learn about who is most at risk for developing acute lymphoblastic leukemia.
Risk Groups And Risk Factors

There is no known concrete reason for why some develop acute lymphoblastic leukemia while others do not. However, there are still risk factors associated with this disease. Heartbreakingly, children aged two to five are the most common victims of this cancer. Furthermore, Caucasian males appear to be affected more often, and those who have previously had chemotherapy or radiation are also at a higher risk. Other major risk factors include exposure to toxic chemicals such as benzene, nuclear waste, or excessive radiation. An individual's chances of developing ALL are increased if a sibling has had it.
Continue reading to learn about how doctors diagnose acute lymphoblastic leukemia and available treatment methods.
Diagnosis And Treatment

Diagnostic tests include a complete blood count, blood smears, and a bone marrow biopsy. The biopsy is taken with a spinal tap (lumbar puncture), and an ultrasound or CT scan can be used to find out if acute lymphoblastic leukemia has spread to other parts of the body. There is no way to prevent ALL, unfortunately, since the direct cause is unknown.
Treatments for this form of cancer include chemotherapy, radiation, and stem cell transplants. Treatment is designed to kill leukemia cells that have spread to other parts of the body. The chance of recovery depends on a range of factors including the patient's age, the number of white blood cells at the time of diagnosis, and other health conditions, if present.
Get the details on how targeted therapy can help in the treatment of acute lymphoblastic leukemia now.
Targeted Therapy Treatment

Some individuals with acute lymphoblastic leukemia will undergo targeted therapy treatment, which utilizes certain drugs that attack specific characteristics of the malignant cells. In some ALL patients, the Philadelphia chromosome is present in the cancerous leukemia cells. About one in every four individuals with ALL will have this chromosome present. This is an irregular chromosome that is made by the switching of genetic material between chromosomes 22 and 9. This mechanism creates a new gene that is called BCR-ABL. Cells with this BCR-ABL gene produce an abnormal protein that assists these cells with rapid growth. The drugs used in the targeted therapy in acute lymphoblastic leukemia treatment are engineered to target the abnormal protein produced by the BCR-ABL gene. These drugs are called tyrosine kinase inhibitors, medications taken daily in the form of pills. In many cases, tyrosine kinase inhibitors are added to chemotherapy to increase the likelihood acute lymphoblastic leukemia will go into remission.
Uncover the details on alternative therapies and clinical trials as they relate to treating acute lymphoblastic leukemia now.
Alternative Therapies And Clinical Trials

Alternative therapies and clinical trials are methods a patient may choose to pursue in the treatment of their case of ALL. Alternative therapies commonly include the use of herbs, special diets, acupuncture, massage, and vitamins. Clinical trials test new treatments and new drugs before the Food and Drug Administration (FDA) approves them as standard treatments. Every new treatment regimen and drug undergoes a series of clinical trial phases before it can become part of standard acute lymphoblastic leukemia therapy. Clinicians and researches carefully design and review their clinical trials to make sure they are as safe and scientifically accurate as possible. In some cases, participation in a carefully and attentively administered clinical trial may be the most beneficial therapy available for an individual affected by ALL. Clinical trials are available for patients in every phase of the disease. This includes patients with advanced acute lymphoblastic leukemia, patients who are newly diagnosed, and patients who are not responding well to other drugs or treatments.
Reveal the treatment phases for acute lymphoblastic leukemia now.
Phases Of Treatment

There are three main phases acute lymphoblastic leukemia treatment is broken down into. ALL treatment usually takes anywhere from two to three years. The objective of the first phase called remission induction is to kill off the leukemia cells in the patient's body. This begins with the patient receiving several chemotherapy drugs over several days. Because the intensive chemotherapy kills off so many of the patient's healthy bone marrow cells in addition to the malignant cells, they will have to stay hospitalized for around a month.
The next phase of treatment is consolidation therapy or treatment to stop the return of acute lymphoblastic leukemia. The goal of consolidation therapy is to eradicate any leukemia cells that were not eliminated initially. This phase includes more chemotherapy and a donor stem cell transplant. The last phase is called maintenance therapy. The goal of this last phase is to keep ALL from returning in the long-term. In order to keep acute lymphoblastic leukemia in remission, the patient will be given low dose chemotherapy and short steroid courses for approximately two years. Intrathecal chemotherapy is also done in blocks during these two years.
Get familiar with the side effects associated with acute lymphoblastic leukemia treatment next.
Side Effects Of Treatment

When an individual is diagnosed with acute lymphoblastic leukemia, they should understand the different potential side effects of treatment. Side effects are unwanted complications that occur as a result of some form of medical treatment. The most prevalent immediate side effects that occur in those undergoing ALL treatment include anemia, fatigue, complete loss of hair, poor defense to infections, frequent bruising, abnormal bleeding, sore mouth, changes in the heart muscle, changes in the menstrual cycle, and decreased sperm production. Late effects of ALL treatment include cataracts or eye lens clouding, heart disease, and infertility. Many immediate side effects will resolve themselves when the patient finishes their course of treatment. There are numerous medications available to help alleviate most adverse side effects while an individual is undergoing treatment for their ALL.
Continue reading to learn about the prognosis of those affected by acute lymphoblastic leukemia.
Prognosis

Most individuals afflicted with any form of cancer, including ALL, want to know what their prognosis happens to be. However, there is no clear line on this. A patient's prognosis is completely individual and is based off factors such as how early doctors caught their acute lymphoblastic leukemia, how they respond to treatment, if they are dealing with other health conditions, age, as well as their overall medical history.
Typically, however, patients younger than thirty, those who reach complete remission within four weeks of starting treatment, ones without negative chromosome abnormalities, and those with a white blood cell count less than thirty thousand for B-cell ALL and less than 100 thousand for T-cell ALL, have a better prognosis than acute lymphoblastic leukemia patients who do not share these characteristics.